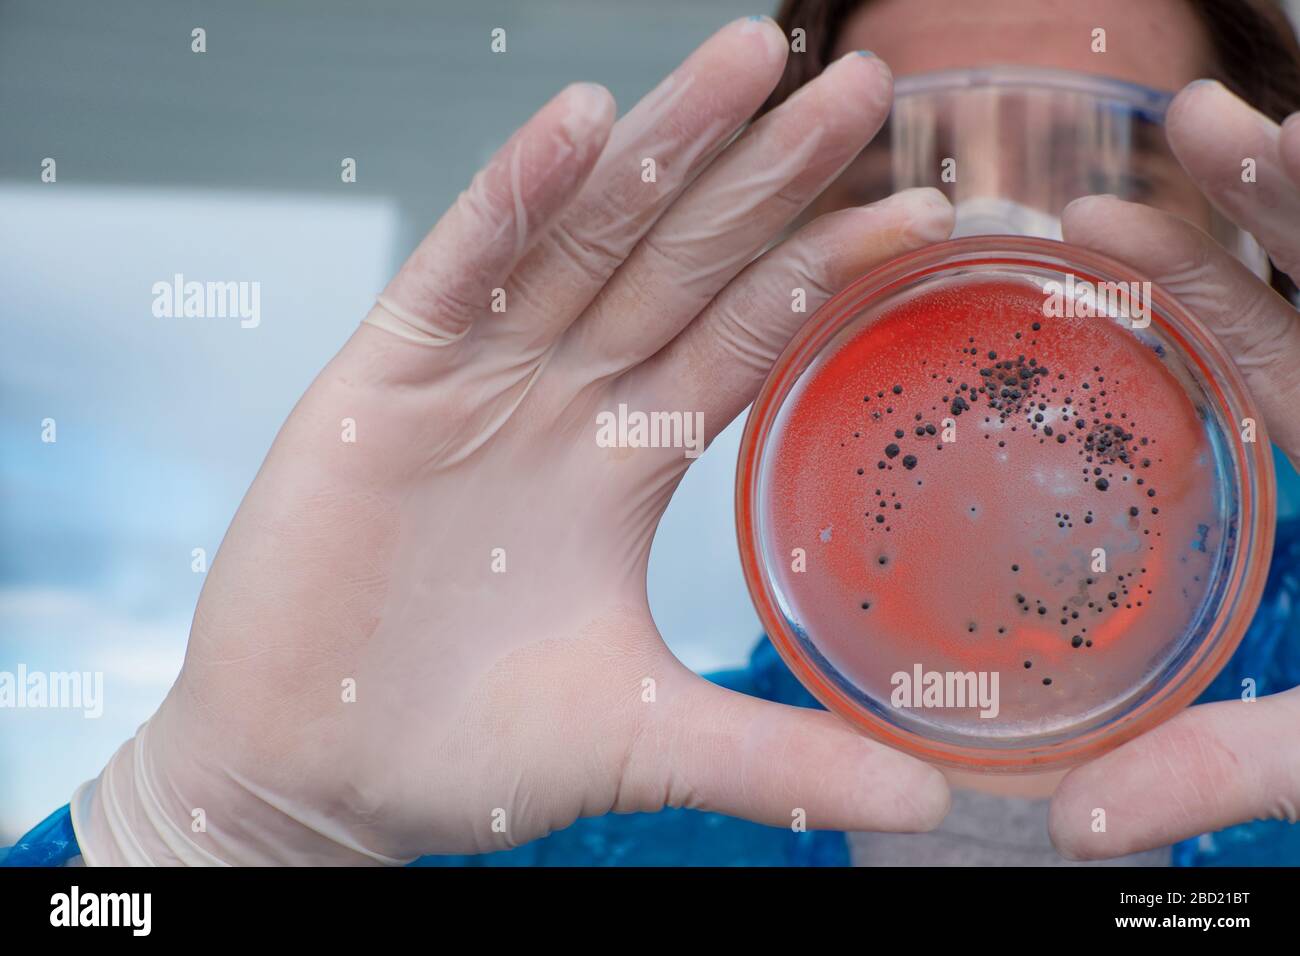
Epidemiologo sviluppa un vaccino e indaga il virus. Patogeni virali e batteriologici. Foto Stock

Si sviluppa Immagini Stock
(17,942)Filtri rapidi:
Si sviluppa Immagini Stock

RME131XP–Febbraio 26, 2012 - STATI UNITI Inventore sviluppa il rivoluzionario motore Non-Pollution ingegnere-scienziato inventore Wallace L. Minto di Sarasota, Florida, ha sviluppato con successo un nuovo non inquinanti a motore per uso in automobili. La sua invenzione ha avuto tanto successo che il Datsun auto aziendale del Giappone hanno firmato un multi-milioni di dollari per la produzione di massa utilizzare nelle loro automobili. Il sistema motore è simile a quella di un motore a vapore tranne che trae il suo potere dal gas ad alta pressione che deriva dal riscaldamento fluoro-carbonio, una sostanza utilizzata come agente di raffreddamento nei frigoriferi

RMMNETRY–Prunus spinosa (prugnolo o sloe) frutta (TS) con Pocket prugna, Taphrina pruni, infezione fungina, il frutto si sviluppa senza una pietra semi

RMG5F0ED–Kukena, il piccolo gorilla della pianura occidentale, raggiunge per un "buon compleanno" caduto banner con cui giocare mentre Kukena celebra il suo primo compleanno il 27 settembre presso i Giardini Zoo di Bristol. Il piccolo Kukena è ancora piccolo, pesa circa 7 kg e si alza per circa 45 cm di altezza e ancora si aggrava alla sua mamma Salome, ma sta diventando più avventuroso come si sviluppa.

RMEAX0GH–Una farfalla pupa si sviluppa all'interno di un alieno cercando crisalide nella foresta pluviale.

RME2FF3J–Germania Amburgo HafenCity che si sviluppa il più importante progetto europeo di pianificazione urbana con la riabilitazione di 155

RMJ2G9R7–Native American Business donna sviluppa il proprio prodotto a base di erbe della linea saponi, lozioni e creme (MR)

RM2RGERK3–Un combattente speciale sviluppa rapidamente una formazione di combattimento durante un'esercitazione di fuoco vivo in mare nella città di Huaibei, provincia di Anhui, Cina, 8 agosto 2023.

RFT5X59F–Interruttore è un dispositivo che si interrompe automaticamente un circuito elettrico se si verifica un guasto, vintage disegno della linea di incisione o illustrazione.

RM2PPK5BF–Scrittura visualizzazione testo saggezza. Corpo fotografico concettuale di conoscenze e principi che si sviluppa entro un periodo specifico

RF2PRAB13–Palline d'acqua in idrogel. Un eccellente modo di anti-stress, depressione, sviluppa abilità motorie nei bambini.

RM2M5BFMN–Un ufficiale di warrant con le forze speciali della Grecia sviluppa una linea 9 nel sistema di addestramento del controllore di attacco del terminale congiunto avanzato (AAJTS) durante il corso di qualificazione del controllore di attacco del terminale congiunto del volo di addestramento di combattimento (CTF) 137th il 12 maggio 2022, alla base della guardia nazionale di Rogers di Will, Oklahoma City. Gli studenti del CTF 137th sperimentano fino a sette profili di missione completi che richiedono chiamate per il supporto aereo da vicino nell'AAJTS, il che è migliorato dalla capacità di avviare e arrestare scenari nel simulatore per adattarsi in modo non possibile durante l'addestramento con aerei dal vivo. (STATI UNITI

RM3CGX4JP–La ragazza tiene la stampa istantanea dalla fotocamera istantanea mentre la stampa sviluppa l'immagine

RM2B7WREH–CureVac GmbH nel parco tecnologico Tuebingen-Reutlingen, centro di avviamento per la biotecnologia, sviluppa un vaccino contro il coronavirus, pandemia COVID-19

RM2WBNDAM–Il progetto NASA Fundamental Aeronautics Hypersonics sviluppa sistemi di propulsione a ciclo combinato e respirazione dell'aria, tra cui la tecnologia a ciclo combinato basato sulla turbina (TBCC), per migliorare l'impulso specifico, la sicurezza e l'efficienza operativa per i sistemi di lancio nello spazio riutilizzabili.

RMKDF29K–L'astronauta della NASA Michael Hopkins aiuta a progettare e sviluppare il boeing cst-100 starliner equipaggio capsule spaziali presso il Johnson Space Center aprile 27, 2017 in Houston Texas. Il lancio commerciale veicolo, progettato per il trasporto di sei-astronauta equipaggi da e per la stazione spaziale internazionale, inizieranno i voli di collaudo nel 2018. (Foto di j.m. eddins jr. via planetpix)

RME138TW–Febbraio 29, 2012 - Il gioco si sviluppa rapidamente in una macchia rugber come i ragazzi del villaggio in stivali da pioggia sfidano il fango per cercare di ottenere il controllo del cofano. Haxy festeggia i suoi 600 anni di vecchio cofano gioco?: presso il villaggio di Lincolnshire Haxy della popolazione locale e dei visitatori guardato o ha preso parte al 600-anno-vecchio ''Cappa Haxy'' gioco, ha detto di aver avuto origine in un capriccio di una signora del ''anor che, quando yeomen locale aveva recuperato egli cappa di seta dopo un lungo inseguimento nel vento, promessa a ciascuna di esse la terra se potevano inventare un gioco simile per essere riprodotti su ogni 6 gennaio

RMMNETW6–Prunus spinosa (prugnolo o sloe) frutta (TS) con Pocket prugna, Taphrina pruni, infezione fungina, il frutto si sviluppa senza una pietra semi

RMG5F0DX–Kukena il gorilla della pianura occidentale del bambino si aggrappa alla sua mamma Salome mentre apre i regali avvolti del cibo mentre Kukena celebra il suo primo compleanno il 27 settembre ai giardini dello zoo di Bristol. Il piccolo Kukena è ancora piccolo, pesa circa 7 kg e si alza per circa 45 cm di altezza e ancora si aggrava alla sua mamma Salome, ma sta diventando più avventuroso come si sviluppa.

RFHGW421–La stratificazione o bande che si sviluppa in un ghiacciaio durante il processo di trasformazione della neve al ghiacciaio.

RME2EKYN–Germania Amburgo HafenCity che si sviluppa il più importante progetto europeo di pianificazione urbana con la riabilitazione di 155

RM2RGERKE–Un combattente speciale sviluppa rapidamente una formazione di combattimento durante un'esercitazione di fuoco vivo in mare nella città di Huaibei, provincia di Anhui, Cina, 8 agosto 2023.

RFT5T8C3–Si tratta di un compatto manopola-come la crescita su un impianto che si sviluppa in una foglia, fiori o sparare, vintage disegno della linea di incisione o illustrazione.

RMPPE6AE–Evento di chiusura di Israele bavarese acceleratore di partenariato (Bipa) nel Strascheg Centro per l'imprenditoria presso Hessstrasse 89. Sulla sinistra, il dottor Dan Shaham, Console Generale dello Stato di Israele, a destra il dottor Klaus-Peter Potthast, dal governo bavarese Ministero dell Economia e dei media, dell'energia e della Tecnologia .

RF2K2H3GR–Anatomia del cuore, aneurisma ventricolare sinistro, rigonfiamento della parete, danno transmurale, si sviluppa aneurisma, dislocazione, formazione di aneurismi, paziente a rischio, rottura, trombo, embolia

RM2M5BFMA–Un ufficiale di warrant con le forze speciali della Grecia sviluppa una linea 9 nel sistema di addestramento del controllore di attacco del terminale congiunto avanzato (AAJTS) durante il corso di qualificazione del controllore di attacco del terminale congiunto del volo di addestramento di combattimento (CTF) 137th il 12 maggio 2022, alla base della guardia nazionale di Rogers di Will, Oklahoma City. Gli studenti del CTF 137th sperimentano fino a sette profili di missione completi che richiedono chiamate per il supporto aereo da vicino nell'AAJTS, il che è migliorato dalla capacità di avviare e arrestare scenari nel simulatore per adattarsi in modo non possibile durante l'addestramento con aerei dal vivo. (STATI UNITI

RM3CGX4MC–La ragazza tiene la stampa istantanea dalla fotocamera istantanea mentre la stampa sviluppa l'immagine

RM2B7WREF–CureVac GmbH nel parco tecnologico Tuebingen-Reutlingen, centro di avviamento per la biotecnologia, sviluppa un vaccino contro il coronavirus, pandemia COVID-19

RMG5G2J1–La gotta è un tipo di artrite dove il gonfiore e il dolore si sviluppa in giunti, specialmente alla base dell'alluce. Nessun modello di rilascio necessarie - fotografo il proprio piede !

RM2B66J2F–Asia , Phnom Penh la capitale cambogiana si sviluppa da alcuni anni la sua voglia di modernità, senza negare il suo passato.

RME137B1–Febbraio 29, 2012 - ci va il primo mate: problemi del motore si sviluppa durante il ventesimo giro di una maratona gara a San Pietroburgo, Florida. Il primo mate risolve il motore così rapidamente che i germogli di artigianato in avanti con risultati disastrosi che il compagno (Jim Payne) viene spinta fuori dalla testa di artigianato prima. La foto mostra il momento drammatico della catastrofe quando Jim Payne è spinta in fuori del suo battito.

RMK3J5JF–Quando lo sceneggiatore Charlie Kaufman cerca di adattare il ladro di orchidee allo schermo, egli sviluppa un grave caso di blocco di scrittori, in Columbia Pictures commedia non convenzionale di adattamento. Credito Foto: courtesy of Columbia Pictures adattamento Nicolas Cage come Charlie Kaufman data: 2002

RMG5F0E2–Kukena il gorilla della pianura occidentale del bambino si aggrappa alla sua mamma Salome mentre apre i regali avvolti del cibo mentre Kukena celebra il suo primo compleanno il 27 settembre ai giardini dello zoo di Bristol. Il piccolo Kukena è ancora piccolo, pesa circa 7 kg e si alza per circa 45 cm di altezza e ancora si aggrava alla sua mamma Salome, ma sta diventando più avventuroso come si sviluppa.

RME2FF3C–Germania Amburgo HafenCity che si sviluppa il più importante progetto europeo di pianificazione urbana con la riabilitazione di 155

RM2H85A9W–Oslo, Norvegia - 27 agosto 2018:Microsoft è una multinazionale americana di tecnologia che sviluppa, produce, concede in licenza e vende software

RM2RGERK1–Un combattente speciale sviluppa rapidamente una formazione di combattimento durante un'esercitazione di fuoco vivo in mare nella città di Huaibei, provincia di Anhui, Cina, 8 agosto 2023.

RFT5R45Y–Una foto di Canbia candida i fiori sono un riflesso in bianco con sei petali. I fiori diventano da soli su steli sottili. La pianta si sviluppa attorno a un pollice
![Alfons Alexander Weidinger, con sede a Monaco, ha sviluppato il sistema di tracciamento satellitare "Asperium Raptor", con il quale i proprietari di falchi possono rintracciare i loro preziosi uccelli in tutto il mondo. L'immagine mostra un trasmettitore su un falco da caccia farcito. [traduzione automatizzata] Foto Stock Alfons Alexander Weidinger, con sede a Monaco, ha sviluppato il sistema di tracciamento satellitare "Asperium Raptor", con il quale i proprietari di falchi possono rintracciare i loro preziosi uccelli in tutto il mondo. L'immagine mostra un trasmettitore su un falco da caccia farcito. [traduzione automatizzata] Foto Stock](https://c8.alamy.com/compit/2amkxcr/alfons-alexander-weidinger-con-sede-a-monaco-ha-sviluppato-il-sistema-di-tracciamento-satellitare-asperium-raptor-con-il-quale-i-proprietari-di-falchi-possono-rintracciare-i-loro-preziosi-uccelli-in-tutto-il-mondo-l-immagine-mostra-un-trasmettitore-su-un-falco-da-caccia-farcito-traduzione-automatizzata-2amkxcr.jpg)
RM2AMKXCR–Alfons Alexander Weidinger, con sede a Monaco, ha sviluppato il sistema di tracciamento satellitare "Asperium Raptor", con il quale i proprietari di falchi possono rintracciare i loro preziosi uccelli in tutto il mondo. L'immagine mostra un trasmettitore su un falco da caccia farcito. [traduzione automatizzata]

RF2K2BECM–Scrittura a mano del testo Prostate Cancer. Concetto che significa cancro si sviluppa nella ghiandola del sistema riproduttivo maschile uomo tenendo lo schermo del telefono cellulare che mostra la tecnologia futuristica.

RMKKGGD8–Sabrina è un film classico degli anni '1950, con Audrey Hepburn, che si concentra sulla trasformazione di una giovane donna e sul triangolo amoroso che si sviluppa tra lei e due uomini di diversa estrazione sociale.

RM2B7WRET–Amministratore delegato Dr. Ingmar Hoerr, CureVac GmbH nel Parco tecnologico Tuebingen-Reutlingen, Centro di avviamento Biotecnologia, sviluppa vaccini contro

RMG5G2KD–La gotta è un tipo di artrite dove il gonfiore e il dolore si sviluppa in giunti, specialmente alla base dell'alluce. Nessun modello di rilascio necessarie - fotografo il proprio piede !

RM2B66J54–Asia , Phnom Penh la capitale cambogiana si sviluppa da alcuni anni la sua voglia di modernità, senza negare il suo passato.

RME13KN9–Mar 02, 2012 - Il brutto anatroccolo con brutto futuro: si inizia la vita con brutto aspetto e il suo carattere si sviluppa in questo modo. La grottesca creatura è un king vulture pulcino. È estremamente raro per questi uccelli per berlina con successo in cattività, ma dopo 60 giorni di incubazione attenta al lo Zoo di Los Angeles in California, questo pulcino schioccato nel mondo con un letto di dimensione king appetito. Ha cominciato vita mangiare 1 mouse un giorno che sarà aumentata a 15 giorno dopo 5 settimane

RME2FF3H–Germania Amburgo HafenCity che si sviluppa il più importante progetto europeo di pianificazione urbana con la riabilitazione di 155

RM2GDW00E–Colonia, Germania - 2 luglio 2017: Microsoft è una multinazionale americana che sviluppa, produce e vende software per computer

RFRWBX48–Luce spica sfocata in autunno rosso backgorund. Accentuato spica close-up si sposta dal vento

RF2B7489W–Forma dell'embrione che un embrione sviluppa da una zigote, disegno a linea d'annata o illustrazione dell'incisione.
![Alfons Alexander Weidinger, con sede a Monaco, ha sviluppato il sistema di tracciamento satellitare "Asperium Raptor", con il quale i proprietari di falchi possono rintracciare i loro preziosi uccelli in tutto il mondo. Nella foto, il palmare. [traduzione automatizzata] Foto Stock Alfons Alexander Weidinger, con sede a Monaco, ha sviluppato il sistema di tracciamento satellitare "Asperium Raptor", con il quale i proprietari di falchi possono rintracciare i loro preziosi uccelli in tutto il mondo. Nella foto, il palmare. [traduzione automatizzata] Foto Stock](https://c8.alamy.com/compit/2amkxey/alfons-alexander-weidinger-con-sede-a-monaco-ha-sviluppato-il-sistema-di-tracciamento-satellitare-asperium-raptor-con-il-quale-i-proprietari-di-falchi-possono-rintracciare-i-loro-preziosi-uccelli-in-tutto-il-mondo-nella-foto-il-palmare-traduzione-automatizzata-2amkxey.jpg)
RM2AMKXEY–Alfons Alexander Weidinger, con sede a Monaco, ha sviluppato il sistema di tracciamento satellitare "Asperium Raptor", con il quale i proprietari di falchi possono rintracciare i loro preziosi uccelli in tutto il mondo. Nella foto, il palmare. [traduzione automatizzata]

RF2K270NH–Ispirazione che mostra il segno del cancro della prostata. Concetto che significa cancro si sviluppa nella ghiandola del sistema riproduttivo maschile Business associate Holding Clipboard documentazione rapporti con la penna.

RF2SW4AM2–La donna nera atletica sviluppa la flessibilità del corpo dopo il fitness a casa, allungando i muscoli rilassanti.

RM2B7WRE7–Amministratore delegato Dr. Ingmar Hoerr, CureVac GmbH nel Parco tecnologico Tuebingen-Reutlingen, Centro di avviamento Biotecnologia, sviluppa vaccini contro

RMG5G2GW–La gotta è un tipo di artrite dove il gonfiore e il dolore si sviluppa in giunti, specialmente alla base dell'alluce. Nessun modello di rilascio necessarie - fotografo il proprio piede !

RM2B66J4B–Asia , Phnom Penh la capitale cambogiana si sviluppa da pochi anni la sua voglia di modernità, senza negare il suo passato. Ritratto del re

RME12K3F–Febbraio 24, 2012 - Francesca l'Asino pigmeo: Francesca, l'asino pigmeo è il più recente arrivo a Whipsnade zoo. Lei è appena tre settimane ed è la figlia di Jack e Jennie, pigmeo di asini da Ceylon. Il soprintendente di Whipsnade scelto Jacko e Jennie come il più piccolo degli asini offerto in modo se Frances si sviluppa per formare lei sarà un piccolo tot per tutta la sua vita. I suoi genitori sono circa le dimensioni di una nuova terra scoperta cane. Pigmeo di asini sono utilizzati come battiti di onere in alcune parti dell'Asia e hanno una reputazione per essere forte e grintosa
RF2ATG2FB–31 gennaio 2020 San Jose / CA / USA - sede centrale di Lumileds in Silicon Valley; Lumileds è un'azienda di illuminazione che sviluppa, produce e distribuisce

RMH52JK8–Un arcobaleno si sviluppa su Knotts Appartamenti in Tynemouth come un uomo cammina il suo cane su South Shields beach.

RME2FF3E–Germania Amburgo HafenCity che si sviluppa il più importante progetto europeo di pianificazione urbana con la riabilitazione di 155

RM2H4C6KN–31 ottobre 2021, Salinas, CA: Vapor si sviluppa sul Lockheed Martin F-35C Lightning II come pilotato dal tenente della Marina degli Stati Uniti Dave Hinkle durante il 40th Annual California International Airshow. (Stan Szeto/immagine dello sport)

RFT5N7HG–Questo mostra embrione, esso è di forma ovale. Impianto di embrione si sviluppa all'interno, vintage disegno della linea di incisione o illustrazione.
![Da sinistra a destra: il prof. Martin Halle (Direttore Medico, Istituto di Medicina dello sport e sport Cardiologia del TUM), Eva-Maria Matzke (Direttore Diakoniewerk München-Maxvorstadt) e Annette Heuser (Amministratore Delegato Fondazione Beisheim) presenti un progetto pilota in cui gli anziani possono mantenere la loro mobilità e fitness anche in età più avanzata con un appositamente sviluppato programma di formazione. [Traduzione automatizzata] Foto Stock Da sinistra a destra: il prof. Martin Halle (Direttore Medico, Istituto di Medicina dello sport e sport Cardiologia del TUM), Eva-Maria Matzke (Direttore Diakoniewerk München-Maxvorstadt) e Annette Heuser (Amministratore Delegato Fondazione Beisheim) presenti un progetto pilota in cui gli anziani possono mantenere la loro mobilità e fitness anche in età più avanzata con un appositamente sviluppato programma di formazione. [Traduzione automatizzata] Foto Stock](https://c8.alamy.com/compit/2abmdtw/da-sinistra-a-destra-il-prof-martin-halle-direttore-medico-istituto-di-medicina-dello-sport-e-sport-cardiologia-del-tum-eva-maria-matzke-direttore-diakoniewerk-munchen-maxvorstadt-e-annette-heuser-amministratore-delegato-fondazione-beisheim-presenti-un-progetto-pilota-in-cui-gli-anziani-possono-mantenere-la-loro-mobilita-e-fitness-anche-in-eta-piu-avanzata-con-un-appositamente-sviluppato-programma-di-formazione-traduzione-automatizzata-2abmdtw.jpg)
RM2ABMDTW–Da sinistra a destra: il prof. Martin Halle (Direttore Medico, Istituto di Medicina dello sport e sport Cardiologia del TUM), Eva-Maria Matzke (Direttore Diakoniewerk München-Maxvorstadt) e Annette Heuser (Amministratore Delegato Fondazione Beisheim) presenti un progetto pilota in cui gli anziani possono mantenere la loro mobilità e fitness anche in età più avanzata con un appositamente sviluppato programma di formazione. [Traduzione automatizzata]

RF2K26FMP–Scrittura a mano segno Prostate Cancer. Business vetrina cancro si sviluppa nella ghiandola di uomo d'affari del sistema riproduttivo maschile indossando casual Standing presentando grafici e idee.

RM2AYAA33–Segno di testo che mostra la progettazione dell'applicazione. La foto concettuale sviluppa software basato sulle esigenze specifiche Silhouette Figura di Peo

RM2B7WRDP–Amministratore delegato Dr. Ingmar Hoerr, CureVac GmbH nel Parco tecnologico Tuebingen-Reutlingen, Centro di avviamento Biotecnologia, sviluppa vaccini contro

RMFFH1N0–Un tattiche speciali Airman, assegnato per gli Stati Uniti Air Force Tattiche speciali Training Squadron, Campo Hurlburt Fla., sollevare i pesi durante una mattina allenamento fisico sessione. Tattiche speciali aviatori hanno una resistenza e condizionata allenatore che sviluppa gli allenamenti personalizzati per la missione unica esigenze fisiche.

RME12K3G–Febbraio 24, 2012 - Francesca l'Asino pigmeo: Francesca, l'asino pigmeo è il più recente arrivo a Whipsnade zoo. Lei è appena tre settimane ed è la figlia di Jack e Jennie, pigmeo di asini da Ceylon. Il soprintendente di Whipsnade scelto Jacko e Jennie come il più piccolo degli asini offerto in modo se Frances si sviluppa per formare lei sarà un piccolo tot per tutta la sua vita. I suoi genitori sono circa le dimensioni di una nuova terra scoperta cane. Pigmeo di asini sono utilizzati come battiti di onere in alcune parti dell'Asia e hanno una reputazione per essere forte e grintosa
RF2ATG293–31 gennaio 2020 San Jose / CA / USA - sede centrale di Lumileds in Silicon Valley; Lumileds è un'azienda di illuminazione che sviluppa, produce e distribuisce